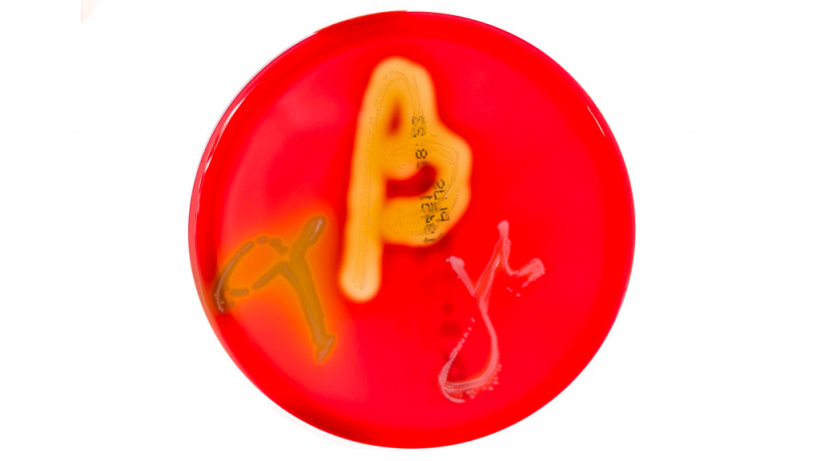
Figura&nbsp;1. Culturas em placas de Petri em &aacute;gar sangue mostrando hem&oacute;lise alfa, beta e gama. Fonte:&nbsp;Mibilehr https://creativecommons.org/licenses/by-sa/4.0/deed.ene&nbsp;

Exames disponíveis:
Cultura bacteriana
- Isolamento de organismos vivos.
- Tipo de amostra: fezes.
- Vantagens:
- Relativamente pouco dispendioso.
- A presença de Brachyspira spp. fortemente beta-hemolítica está associada à virulência.
Figura 1. Culturas em placas de Petri em ágar sangue mostrando hemólise alfa, beta e gama. Fonte: Mibilehr https://creativecommons.org/licenses/by-sa/4.0/deed.ene

Tabela 1: Relação entre a beta-hemólise na Brachyspira spp. e a doença
| Brachyspira spp. | Beta-hemólise | Doença |
|---|---|---|
| B. hyodysenteriae | Forte | Lesões da disentería suína |
| B. hampsonii | Forte | Lesões da disentería suína |
| B. suanatina | Forte | Lesões da disentería suína |
| B. pilosicoli | Fraca | Colite por espiroquetas |
| B. murdochii | Fraca | Colite por espiroquetas |
| B. intermedia | Fraca | Colite por espiroquetas |
| B. innocens | Fraca | Não patogénica |
- Contras:
- Menos sensível do que o teste PCR.
- Crescimento lento (até 10 dias).
- Requer cultura anaeróbia.
- Algumas estirpes menos virulentas podem ser encontradas em explorações sem sinais clínicos ou lesões.
Susceptibilidade antimicrobiana
- Exame in vitro: capacidade de um organismo vivo crescer sob concentrações específicas de diferentes antimicrobianos.
- Tipo de amostra: fezes.
- Prós:
- Identificação da susceptibilidade ou resistência a estirpes específicas a agentes antimicrobianos comuns.
- Contras:
- Requer um isolado bacteriano.
- Os testes in vitro podem diferir ligeiramente dos resultados in vivo.
- Alguns antimicrobianos específicos podem não ser incluídos ou podem exigir testes especiais separados.
- Custo moderado.
- Os resultados demoram 7 dias.
Histopatologia
- Avalia a presença de lesões nos tecidos que podem confirmar a presença de doença.
- Tipo de amostra: tecidos.
- Prós:
- As lesões histopatológicas podem ser altamente sugestivas se forem encontradas muitas espiroquetas perto de lesões intestinais.
- Pode detectar formas ligeiras da doença.
- Contras:
- É necessária a fixação em formol dos tecidos intestinais de um animal recentemente morto.
- As lesões são semelhantes às de outras doenças.
Esfregaços de impressão
- Detecta a presença de bactérias.
- Tipos de amostras: tecido do intestino grosso, fezes.
- Prós:
- Fácil de executar.
- Coloração não específica.
- Microscopia de campo escuro.
- O diagnóstico provisório pode ser feito através da detecção de um grande número de espiroquetas.

Figura 2. Gráfico que mostra a forma espiroqueta da Brachyspira spp. Fonte: Y_tambe. https://creativecommons.org/licenses/by-sa/3.0/deed.en
- Pode identificar quantidades baixas, moderadas ou altas de bactérias presentes.
- Contras:
- Exige a presença de um número significativamente maior de bactérias do que a cultura ou a PCR.
- Não avalia a capacidade hemolítica dos isolados e, por conseguinte, não distingue entre estirpes não patogénicas, colite espiroqueta e disenteria suína.
Reacção em cadeia da polimerase (PCR)
- Detecta a presença de uma sequência específica de ácido nucleico (ADN) bacteriano.
- Tipos de amostras: tecido intestinal, esfregaços fecais, fezes.
- Vantagens:
- Elevada sensibilidade.
- A quantificação da PCR está associada à presença de lesões.
- Custo moderado.
- As amostras de fezes ou de tecido podem frequentemente ser combinadas para reduzir os custos e minimizar a perda de sensibilidade (especialmente no que respeita à relevância clínica).
- Contras:
- Alta sensibilidade – confirma a presença de bactéria mas não de doença.
- São necessários primers adequados para detectar e diferenciar entre Brachyspira spp.
Ensaio por imunoabsorção ligado a enzimas (ELISA)
- Detecta a presença de anticorpos.
- Tipo de amostra: soro.
- Prós:
- Pode detetar a infecção ao nível da exploração agrícola.
- Os anticorpos podem durar vários meses.
- Os níveis de IgG no soro estão correlacionados com a duração dos sinais clínicos.
- Contras:
- Os testes não estão imediatamente disponíveis.
- Baixa sensibilidade e especificidade.
- Utilizados para a detecção a nível da exploração e não para o diagnóstico individual do animal.
- Os anticorpos específicos e o momento da detecção podem variar ligeiramente entre os kits disponíveis no mercado.
- Muitas vezes, os antigénios utilizados podem ser específicos de determinadas espécies de Brachyspira.
- Não existe correlação entre os níveis de anticorpos e a protecção.
- Desconhece-se a protecção cruzada entre Brachyspira spp.
Interpretação de resultados:
Cultura bacteriana
- Positivo: presença de bactérias.
- Beta-hemólise forte - disenteria suína.
- Beta-hemólise fraca - colite por espiroquetas ou não patogénica.
- Negativo: Negativo, o animal pode ter sido previamente tratado com antibióticos ou ter sido tratado demasiado tarde na infecção.
Susceptibilidade antimicrobiana
- Susceptível: possível boa escolha para tratamento se o antimicrobiano conseguir atingir o tecido-alvo.
- Resistente: deve ser selecionado um antimicrobiano diferente.
CIM: se for efectuada a CIM (concentração inibitória mínima), certifique-se de que o antimicrobiano seleccionado atinge o valor de CIM indicado no órgão-alvo.
Histopatologia
- Positivo: A presença de espiroquetas junto das lesões constitui um diagnóstico presumível.
- Negativo: Não há lesões intestinais.
Esfregaço de impressão
- Número de espiroquetas presentes:
- Elevado: altamente sugestivo de doença.
- Moderado: interpretação variável.
- Baixo: valor duvidoso (pode ser uma condição não patogénica ou crónica).
- Não presente: animal possivelmente tratado anteriormente com antibióticos ou contribuinte não significativo.
PCR
- Positivo: confirma a presença de bactéria.
- Negativo: Negativo ou infecção muito antiga para detectar a bactéria ou animal tratado previamente com antibióticos.
ELISA
- Positivo: Exposición anterior (>2-4 semanas) a vacina ou bactéria de campo.
- Negativo:
- Negativo a vacina ou bactéria de campo.
- Infecção muito antiga para ser detectada.
- O uso de antibióticos pode inibir o crescimento bacteriano e diminuir a resposta imunitária.
Cenários:
Porcos de engorda com diarreia (aguda)

- Recolher amostras fecais de 10 ou mais suínos com diarreia não tratados com antibióticos e submetê-las a cultura bacteriana e PCR em grupos de 5.
- Efetuar a necropsia de 1-3 suínos mortos recentemente ou eutanasiar os suínos com diarreia. Avaliar macroscopicamente o intestino grosso (especialmente o ceco e o cólon espiral) e fixá-lo em formalina para histopatologia.
Antecedentes crónicos de diagnóstico de disenteria suína mas sem sinais clínicos observados
- Recolher amostras de fezes de 4-6 parques e enviar para PCR.
- Recolher amostras de 15-20 suínos às 14 e 18 semanas de idade.
- Duas abordagens à recolha:
- Transversal - recolha de amostras de diferentes grupos etários ao mesmo tempo (obtém resultados mais rapidamente).
- Longitudinal - recolha dos mesmos suínos ao longo do tempo (resultados mais exactos).
- Análise de amostras de soro por ELISA.





















